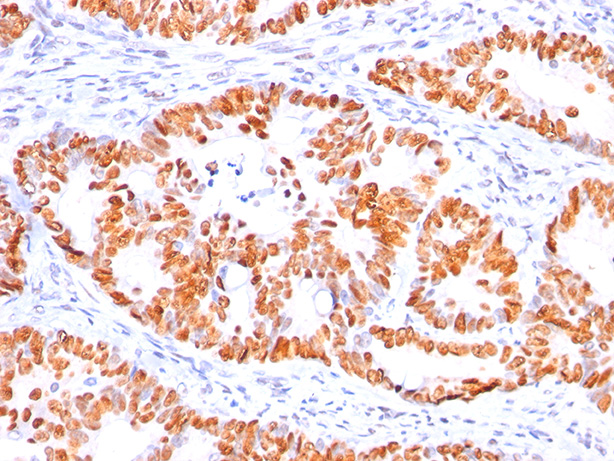

> Antigen, Antibodies, ELISA, Western Blot > Primary Antibody > Monoclonal Antibodies > p53 Tumor Suppressor Protein Antibody - With BSA and AzideBrand |
Leading Biology | Catalog Number |
AMM00067G |
Product Type |
Monoclonal Antibodies | Field of Research |
|
Product Overview |
We constantly strive to ensure we provide our customers with the best antibodies. As a result of this work we offer this antibody in purified format.
We are in the process of updating our datasheets. If you have any questions regarding this update, please feel free to contact our technical support team.
This product is a high quality p53 Tumor Suppressor Protein Antibody - With BSA and Azide.
|
||
Molecular Weight |
53kDa
|
||
Cellular Localization |
Antigen Cellular Localization:
Cytoplasm. Nucleus. Nucleus, PML body. Endoplasmic reticulum. Mitochondrion matrix. Note=Interaction with BANP promotes nuclear localization. Recruited into PML bodies together with CHEK2. Translocates to mitochondria upon oxidative stress Isoform 2: Nucleus. Cytoplasm. Note=Localized mainly in the nucleus with minor staining in the cytoplasm Isoform 4: Nucleus. Cytoplasm. Note=Predominantly nuclear but translocates to the cytoplasm following cell stress Isoform 8: Nucleus. Cytoplasm. Note=Localized in both nucleus and cytoplasm in most cells. In some cells, forms foci in the nucleus that are different from nucleoli
|
||
Host |
Mouse
|
||
Species Reactivity |
Human
|
||
Target |
Recombinant human wild-type p53 protein
|
||
Clone |
BP53-12
|
||
Isotype |
IgG2a
|
||
Symbol |
P53
|
||
GeneID |
|||
UniProt ID |
|||
Function |
Acts as a tumor suppressor in many tumor types; induces growth arrest or apoptosis depending on the physiological circumstances and cell type. Involved in cell cycle regulation as a trans-activator that acts to negatively regulate cell division by controlling a set of genes required for this process. One of the activated genes is an inhibitor of cyclin-dependent kinases. Apoptosis induction seems to be mediated either by stimulation of BAX and FAS antigen expression, or by repression of Bcl-2 expression. In cooperation with mitochondrial PPIF is involved in activating oxidative stress-induced necrosis; the function is largely independent of transcription. Induces the transcription of long intergenic non-coding RNA p21 (lincRNA-p21) and lincRNA- Mkln1. LincRNA-p21 participates in TP53-dependent transcriptional repression leading to apoptosis and seem to have to effect on cell-cycle regulation. Implicated in Notch signaling cross-over. Prevents CDK7 kinase activity when associated to CAK complex in response to DNA damage, thus stopping cell cycle progression. Isoform 2 enhances the transactivation activity of isoform 1 from some but not all TP53-inducible promoters. Isoform 4 suppresses transactivation activity and impairs growth suppression mediated by isoform 1. Isoform 7 inhibits isoform 1-mediated apoptosis.
|
||
Summary |
Recognizes a 53kDa protein, which is identified as p53 suppressor gene product. It reacts with the mutant as well as the wild form of p53 under denaturing and non-denaturing conditions. Its epitope maps within the N-terminus (aa 20-25) of p53 oncoprotein. p53 is a tumor suppressor gene expressed in a wide variety of tissue types and is involved in regulating cell growth, replication, and apoptosis. It binds to MDM2, SV40 T antigen and human papilloma virus E6 protein. Positive nuclear staining with p53 antibody has been reported to be a negative prognostic factor in breast carcinoma, lung carcinoma, colorectal, and urothelial carcinoma. Anti-p53 positivity has also been used to differentiate uterine serous carcinoma from endometrioid carcinoma as well as to detect intratubular germ cell neoplasia. Mutations involving p53 are found in a wide variety of malignant tumors, including breast, ovarian, bladder, colon, lung, and melanoma.
|
||
Form |
Liquid. Purified antibody supplied in 1x PBS buffer with 0.09% (w/v) sodium azide and 2% sucrose. |
||
Storage & Stability |
Store at +4°C short term. For long-term storage, aliquot and store at -20°C or below. Stable for 12 months at -20°C. Avoid repeated freeze-thaw cycles.
|
||
Applications |
WB, IHC, IF, FC, IP, E
|
||
Images |
Formalin-paraffin human colon carcinoma stained with p53 MAb (BP53-12). 
Western blot analysis of p53 1) A431 2) MCF7 and 3) HEK293 lysate probed with p53 Ab (BP53-12). |
||
Specification |
|||
Quantity |
|
||
| Select | Brand | Catalog No. | Product Name | Pack Size | Type | Field of Research | Specification | Quantity | Price(USD) | |
| 1 | Leading Biology | APG02467G | CCK4 / PTK7 Antibody (clone 4F9) | 50 μl | Monoclonal Antibodies |
|
$495.00 | Add Ask | ||
| 2 | Leading Biology | AMM04683G | GALT Antibody (clone 4C11) | 50 μg | Monoclonal Antibodies |
|
$545.00 | Add Ask | ||
| 3 | Leading Biology | AMM01402G | Vimentin (Mesenchymal Cell Marker) Antibody - With BSA and Azide | 50 ug | Monoclonal Antibodies |
|
$395.00 | Add Ask | ||
| 4 | Leading Biology | APR08280G | LTA4H / LTA4 Antibody (clone 9G8) | 50 μl | Monoclonal Antibodies |
|
$495.00 | Add Ask | ||
| 5 | Leading Biology | AMM00172G | CD1a / HTA1 (Mature Langerhans Cells Marker) Antibody - With BSA and Azide | 50 ug | Monoclonal Antibodies |
|
$395.00 | Add Ask | ||
| 6 | Leading Biology | AMM05750G | CEBPA Antibody | 100 μl | Monoclonal Antibodies |
|
$545.00 | Add Ask |
 Leading Biology Inc.
2600 Hilltop DR, Building G, B Suite C138
Richmond, CA, 94806
Tel: 1-661-524(LBI)-0262
Email: info@leadingbiology.com
Leading Biology Inc.
2600 Hilltop DR, Building G, B Suite C138
Richmond, CA, 94806
Tel: 1-661-524(LBI)-0262
Email: info@leadingbiology.com
Complete this form and click send to ask us a question, request a quote or simply say hello.

You have 0 item in your cart

You have 0 item in your inquiry list
